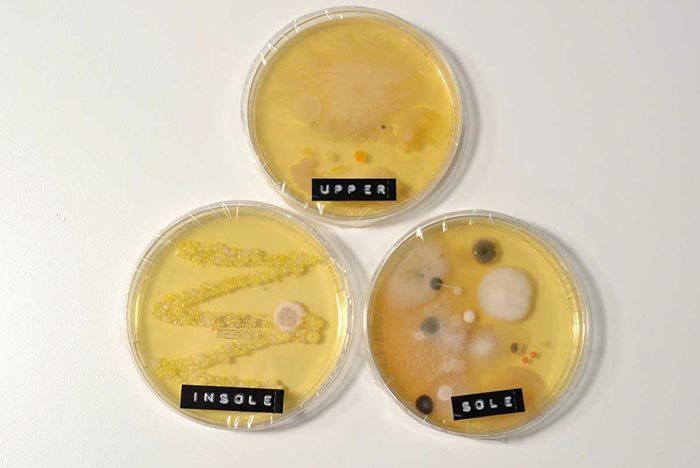
air force 1 no socks

product description:

Nike Air Force 1 React With vs Without
air force 1 no socks Discover cheap clothes, shoes and accessories for men at Our shop Outlet. Shop the latest menswear collection at cheap prices.

Nike Air Force 1 React With vs Without
air force 1 no socks Discover cheap clothes, shoes and accessories for men at Our shop Outlet. Shop the latest menswear collection at cheap prices.
Product reviews:



Harlan
2026-03-06 iphone 6s Plus
Moss Point by Devin Booker Commercial air force 1 no socks
air force 1 no socks

Toby
2026-02-24 iphone X
Nike Nike Air Force 1 07 Virgil x MOMA air force 1 no socks
air force 1 no socks

Philip
2026-02-27 iphone XS Max
Black Air Force 1 Became Sneaker air force 1 no socks
air force 1 no socks

Customer Reviews:
| Full Name: | |
| Title: | |
| Description: | |
| Rating Value: | |
| Time: | 2026-03-06 19:58:42 |
Customers who viewed this item also viewed: